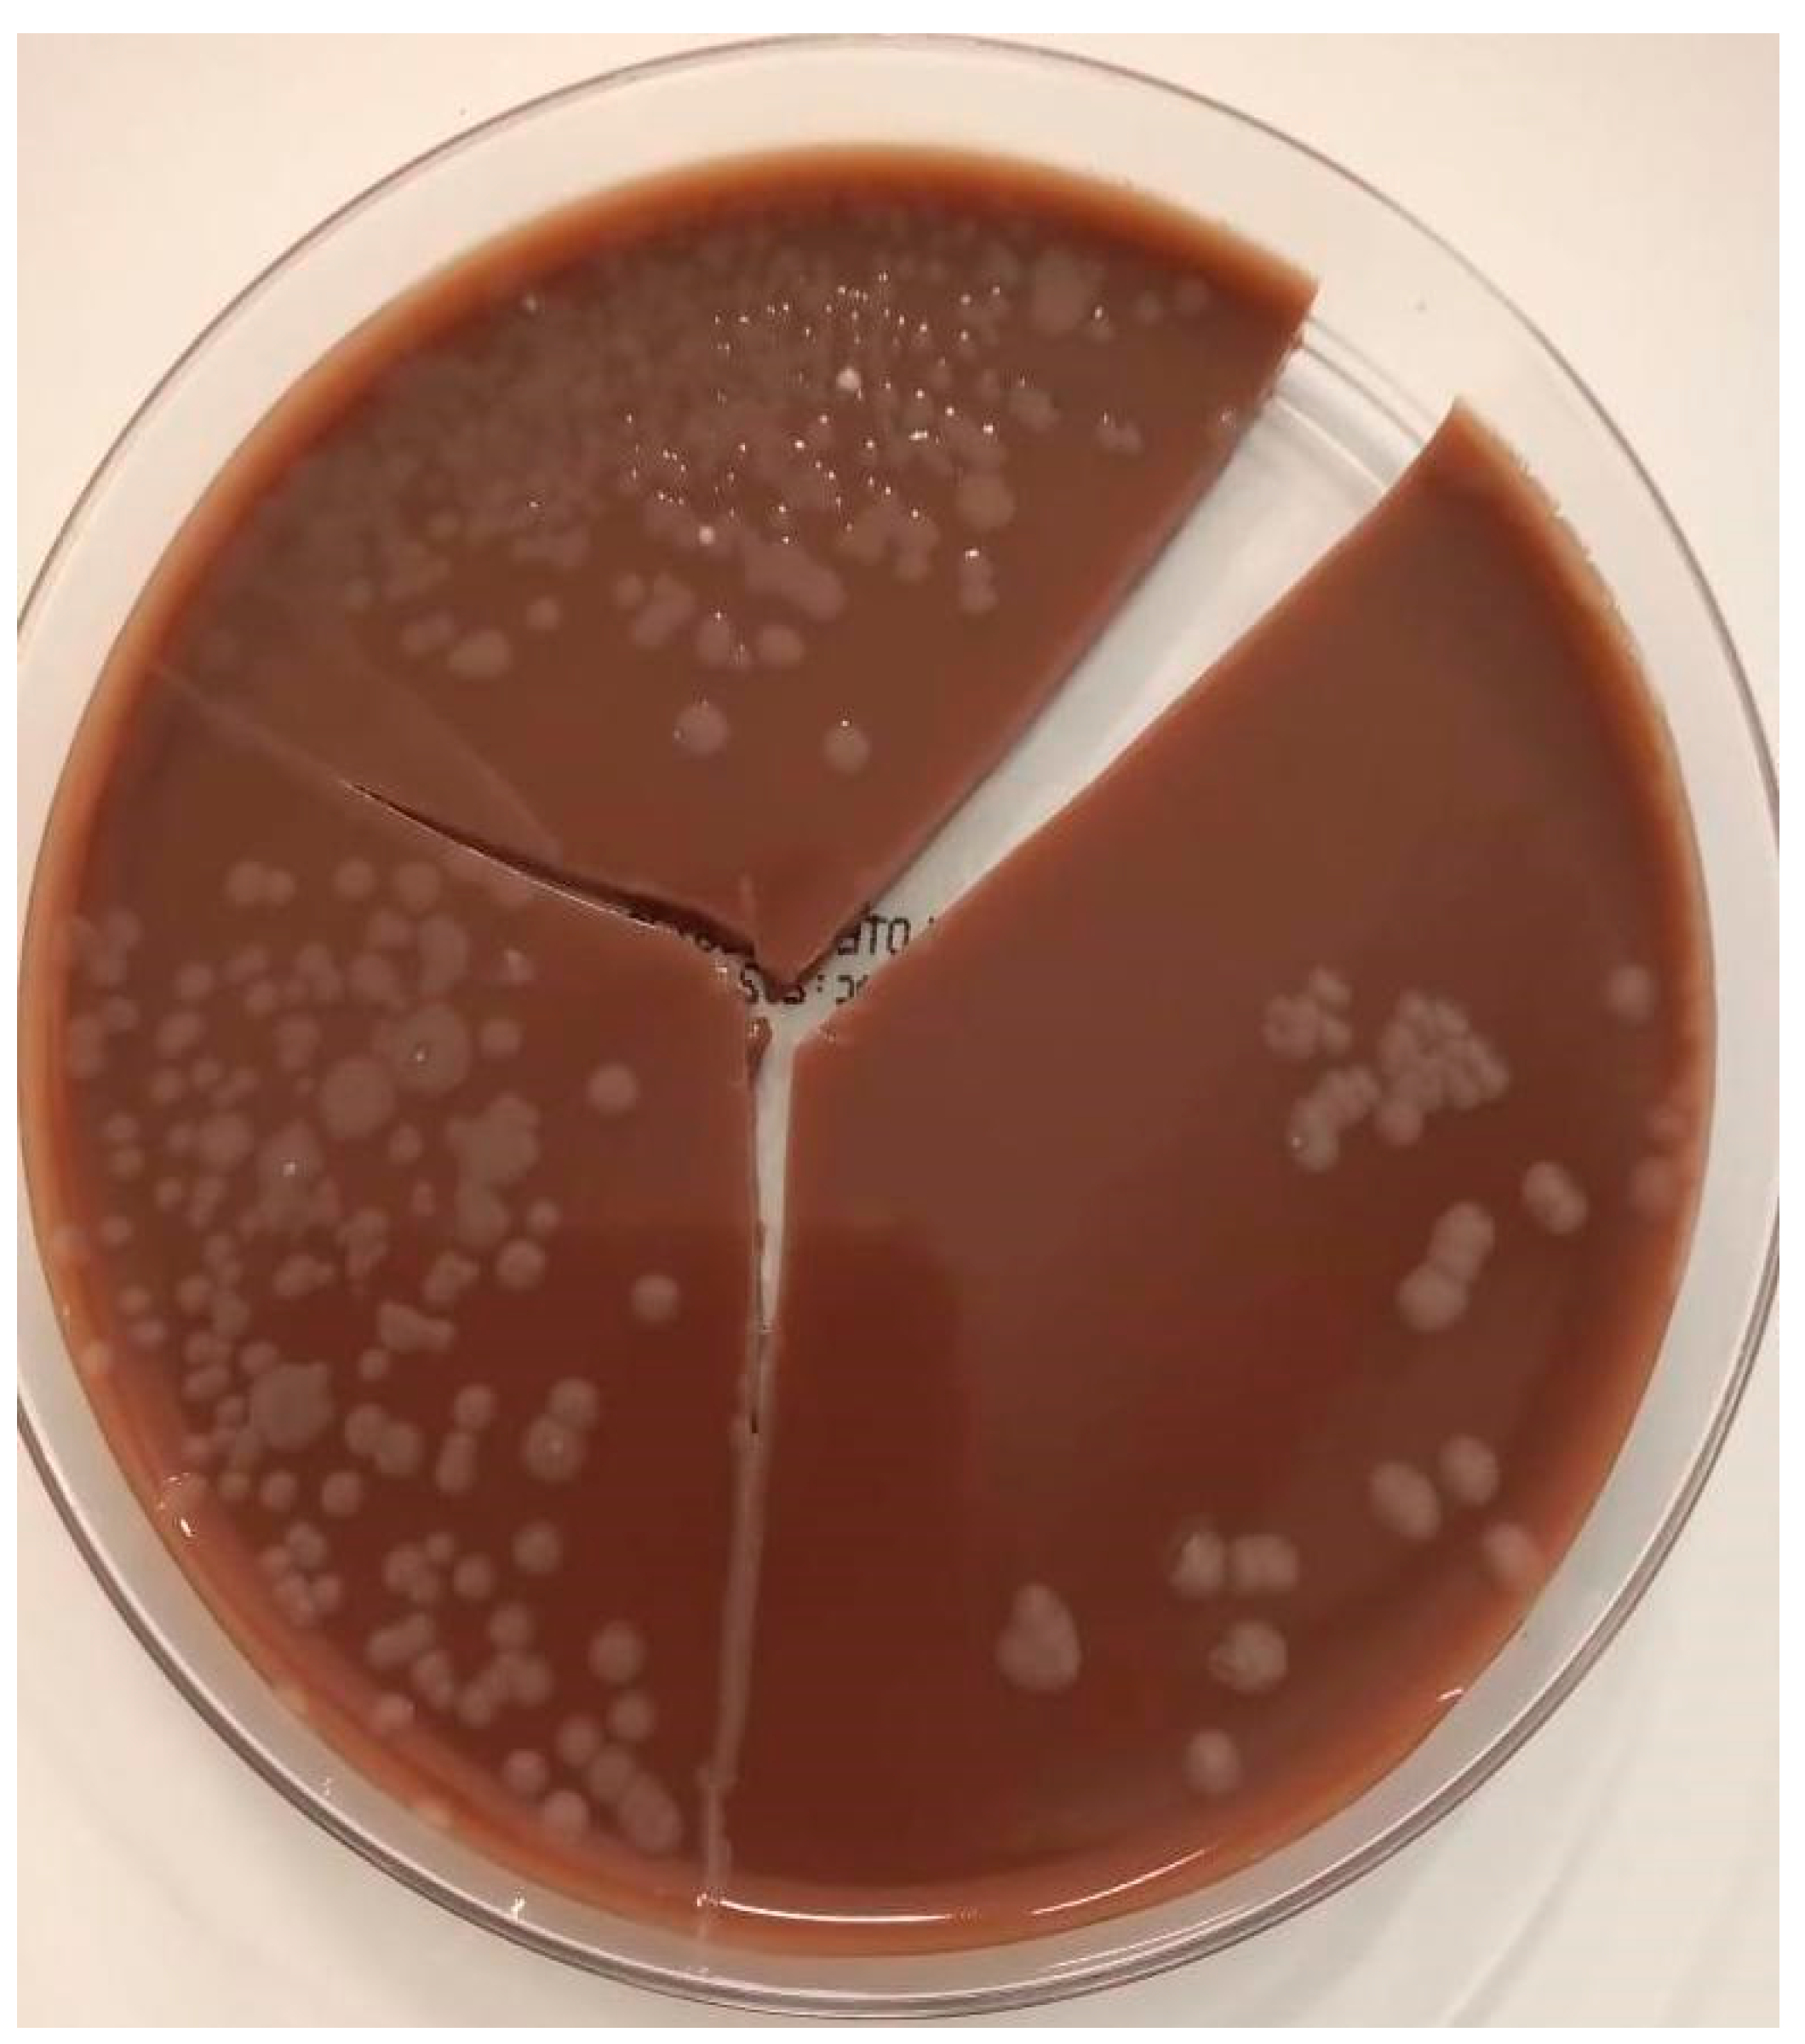

Pandoraea pnomenusa Superinfection in a Patient with SARS-CoV-2 Pneumonia: First Case in the Literature
Abstract
:1. Introduction
2. Case Report
3. Discussion
4. Conclusions
Author Contributions
Funding
Institutional Review Board Statement
Informed Consent Statement
Data Availability Statement
Conflicts of Interest
Abbreviations
| CLSI | Clinical & Laboratory Standards Institute |
| COVID-19 | Coronavirus disease 2019 |
| EUCAST | European Committee on Antimicrobial Susceptibility Testing |
| MALDI-TOF | Matrix-assisted laser desorption/ionization–time of flight |
| PCR | Polymerase chain reaction |
| SARS-CoV-2 | Severe acute respiratory syndrome coronavirus 2 |
References
- Coenye, T.; Liu, L.; Vandamme, P.; Lipuma, J.J. Identification of Pandoraea species by 16S ribosomal DNA-based PCR assays. J. Clin. Microbiol. 2001, 39, 4452–4455. [Google Scholar] [CrossRef] [Green Version]
- Stryjewski, M.E.; LiPuma, J.J.; Messier, R.H.; Reller, L.B.; Alexander, B.D. Sepsis, Multiple Organ Failure, and Death Due to Pandoraea pnomenusa Infection after Lung Transplantation. J. Clin. Microbiol. 2003, 41, 2255. [Google Scholar] [CrossRef] [PubMed] [Green Version]
- Schneider, I.; Queenan, A.M.; Bauernfeind, A. Novel Carbapenem-Hydrolyzing Oxacillinase OXA-62 from Pandoraea pnomenusa. Antimicrob. Agents Chemother. 2006, 50, 1330. [Google Scholar] [CrossRef] [PubMed] [Green Version]
- Falces-Romero, I.; Gutiérrez-Arroyo, A.; Romero-Gómez, M.P. Bacteriemia asociada a catéter por Pandoraea pnomenusa en un paciente pediátrico con leucemia aguda linfoblástica. Med. Clínica 2016, 147, 132. [Google Scholar] [CrossRef] [PubMed]
- Ambrose, M.; Malley, R.C.; Warren, S.J.C.; Beggs, S.A.; Swallow, O.F.E.; McEwan, B.; Stock, D.; Roddam, L.F. Pandoraea pnomenusa Isolated from an Australian Patient with Cystic Fibrosis. Front. Microbiol. 2016, 7, 692. [Google Scholar] [CrossRef] [PubMed]
- Gawalkar, A.A.; Kasinadhuni, G.; Kanaujia, R.; Rajan, P.; Vijay, J.; Revaiah, P.C.; Ray, P.; Vijayvergiya, R. Prosthetic aortic valve dehiscence following infective endocarditis by a rare bacterium—Pandoraea pnomenusa. J. Cardiol. Cases 2020, 24, 27–29. [Google Scholar] [CrossRef] [PubMed]
- Bodendoerfer, E.; Personnic, N.; Mestres, C.A.; Wilhelm, M.J.; Meyer, L.; Hasse, B. Possible Prosthetic Valve Endocarditis by Pandoraea pnomenusa and Specific Virulence Mechanisms. Infect. Drug Resist. 2021, 14, 1319. [Google Scholar] [CrossRef] [PubMed]
- Jørgensen, I.M.; Johansen, H.K.; Frederiksen, B.; Pressler, T.; Hansen, A.; Vandamme, P.; Høiby, N.; Koch, C. Epidemic spread of Pandoraea apista, a new pathogen causing severe lung disease in cystic fibrosis patients. Pediatric Pulmonol. 2003, 36, 439–446. [Google Scholar] [CrossRef] [PubMed]
- Bayjanov, J.R.; Ekkelenkamp, M.B.; Rogers, M.R.; Cantón, R.; Benaissa-Trouw, B.J.; Díez-Aguilar, M.; Tunney, M.; Fluit, A.C. Whole-genome analysis of Pandoraea species strains from cystic fibrosis patients. Future Microbiol. 2019, 14, 1357–1367. [Google Scholar] [CrossRef] [PubMed]
- Ee, R.; Ambrose, M.; Lazenby, J.; Williams, P.; Chan, K.G.; Roddam, L. Genome Sequences of Two Pandoraea pnomenusa Isolates Recovered 11 Months Apart from a Cystic Fibrosis Patient. Genome Announc. 2015, 3, 1389–1403. [Google Scholar] [CrossRef] [PubMed] [Green Version]
- Oliver, A.; Alarcón, T.; Caballero, E.; Cantón, R. Diagnóstico microbiológico de la colonización-infección broncopulmonar en el paciente con fibrosis quística. Enferm. Infecc. Microbiol. Clin. 2009, 27, 89. [Google Scholar] [CrossRef] [PubMed]
- Pimentel, J.D.; MacLeod, C. Misidentification of Pandoraea sputorum Isolated from Sputum of a Patient with Cystic Fibrosis and Review of Pandoraea Species Infections in Transplant Patients. J. Clin. Microbiol. 2008, 46, 3165. [Google Scholar] [CrossRef] [PubMed] [Green Version]
- Fernández-Olmos, A.; Morosini, M.I.; Lamas, A.; García-Castillo, M.; García-García, L.; Cantón, R.; Máiz, L. Clinical and Microbiological Features of a Cystic Fibrosis Patient Chronically Colonized with Pandoraea sputorum Identified by Combining 16S rRNA Sequencing and Matrix-Assisted Laser Desorption Ionization–Time of Flight Mass Spectrometry. J. Clin. Microbiol. 2012, 50, 1096. [Google Scholar] [CrossRef] [PubMed] [Green Version]
- Tabatabaei, M.; Dastbarsar, M.; Moslehi, M.A. Isolation and identification of Pandoraea spp. From bronchoalveolar lavage of cystic fibrosis patients in Iran. Ital. J. Pediatrics 2019, 45, 118. [Google Scholar] [CrossRef] [PubMed] [Green Version]
- EM100 Connect—CLSI M60 ED2:2020 n.d. Available online: http://em100.edaptivedocs.net/GetDoc.aspx?doc=CLSI%20M60%20ED2:2020&scope=user (accessed on 11 March 2022).
- Bridges, J.P.; Vladar, E.K.; Huang, H.; Mason, R.J. Respiratory epithelial cell responses to SARS-CoV-2 in COVID-19. Thorax 2022, 77, 203–209. [Google Scholar] [CrossRef] [PubMed]
- Tesse, R.; Cardinale, F.; Santostasi, T.; Polizzi, A.; Manca, A.; Mappa, L.; Iacoviello, G.; De Robertis, F.; Logrillo, V.P.; Armenio, L. Association of β-defensin-1 gene polymorphisms with Pseudomonas aeruginosa airway colonization in cystic fibrosis. Genes Immunity 2008, 9, 57–60. [Google Scholar] [CrossRef] [PubMed] [Green Version]
- Dugger, D.T.; Fung, M.; Zlock, L.; Caldera, S.; Sharp, L.; Hays, S.R.; Singer, J.P.; Leard, L.E.; Golden, J.A.; Shah, R.J.; et al. Cystic Fibrosis Lung Transplant Recipients Have Suppressed Airway Interferon Responses during Pseudomonas Infection. Cell Rep. Med. 2020, 1, 100055. [Google Scholar] [CrossRef] [PubMed]
- Nag, V.L.; Kaur, N. Superinfections in COVID-19 Patients: Role of Antimicrobials. Dubai Med. J. 2021, 4, 117–126. [Google Scholar] [CrossRef]

| Laboratory | Laboratory Reference Ranges | Hospital Admission (Day 1) | ICU Admission (Day 3) | ICU Deterioration (Day 8) | Hospital Discharge (Day 41) |
|---|---|---|---|---|---|
| White blood cell count (×103 uL) | 5–10 | 9.09 | 9.79 | 12.6 | 11.99 |
| Neutrophils (×103 uL) | 1.82–7.42 | 8.44 (92 %) | 8.74 (89.4%) | 11.7 (92.9%) | 9.34 (77.9%) |
| Lymphocytes (×103 uL) | 1.5–4 | 0.40 (4.4%) | 0.68 (6.9 %) | 0.43 (3.2%) | 1.42 (11.8%) |
| Hematocrit (%) | 40–54 | 42 | 43 | 35.9 | 29 |
| Hemoglobin (g/dL) | 13.5–18 | 14.4 | 14 | 11.6 | 9.9 |
| MCV (fL) | 86–96 | 89.9 | 95.8 | 95.7 | 90.1 |
| MCH (pg) | 25–31 | 30.8 | 31 | 30.9 | 30.6 |
| MCHC (g/dL) | 32–38 | 34.3 | 32.3 | 32.3 | 33.9 |
| RDW (%) | 11–15 | 13.9 | 14.3 | 14.3 | 14.1 |
| Platelets (×103 uL) | 150–450 | 257 | 337 | 280 | 356 |
| C-reactive protein (mg/dL) | 0.6–5 | 36.4 | 250 | 250.4 | 26 |
| Blood urea nitrogen (mg/dL) | 8–23 | 50.2 | 45.9 | 46.5 | 34.8 |
| Creatinine (mg/dL) | 0.67–1.17 | 1.11 | 1.54 | 1.54 | 1.52 |
| D-dimer (ng/mL) | 190–499 | 4610 | 6400 | - | - |
| pH | 7.39–7.47 | 7.48 | 7.23 | 7.34 | 7.5 |
| PCO2 (mmHg) | 29.4–39.8 | 29 | 58 | 50 | 41 |
| PO2 (mmHg) | 55.2–74 | 65 | 77 | 67 | 84 |
| BE (mmol/L) | −3–3 | −0.8 | −3.3 | 0.6 | 8.1 |
| HCO3 (mmol/L) | 19.6–25.6 | 21.3 | 24.3 | 27 | 31.3 |
| Lactate (mmol/L) | 0.6–2.1 | 1.9 | 1.2 | 0.4 | - |
| Microorganism | Colony-Forming Unit (CFU) | |
|---|---|---|
| Pandoraea pnomenusa | 35 × 105 | |
| Antibiotic | Disk diffusion | Interpretation |
| Ciprofloxacin (5 μg) | 22 mm | Intermediate a |
| Co-trimoxazole (1.25/23.75 μg) | 30 mm | Sensitive b |
| Author and Year | Title | Age and Gender | Clinical Records | Diagnosis | Bacteremia/Sepsis | Resistance Pattern | Management | Clinical Outcome |
|---|---|---|---|---|---|---|---|---|
| Falces—Romero I, et al. [4]—2016 | Bacteriemia asociada a catéter por Pandoraea pnomenusa en un paciente pediátrico con leucemia aguda linfoblástica | 10 months | Pre-B-cell acute lymphoblastic leukemia in a newborn, central venous catheter user. | Blood cultures, positive on day 4. MALDI-TOF identification | Yes/Yes | Sensitive: MIN, IPM | CMX + dexamethasone for 5 days, then CEF for 4 days, then IMI for 10 days | Recovery after 10 days of antibiotic |
| Ambrose M, et al. [5]—2016 | Pandoraea pnomenusa Isolated from an Australian Patient with Cystic Fibrosis | 26-year-old male | Cystic fibrosis with chronic infection by P. aeruginosa, managed with TOB, TZP, AZI | Sputum culture, positive on day 3. MALDI-TOF identification | No/No | Sensitive: IPM, CMX Resistant: CAZ, CIP, GEN, TOB, TZP, AMC, AZM, CRO, MEM, CL, TMP | Pre-hospital management with TOB + TZP + AZI. On day 4 of admission, management was changed to IMI + CMX, and one day later, VAN and CAS were added for a total of 5 days. | Death on day 11 of admission |
| Gawalkar A, et al. [6]—2020 | Prosthetic aortic valve dehiscence following infective endocarditis by a rare bacterium–Pandoraea pnomenusa | 42-year-old male | Mechanic valve replacement 20 years ago due to rheumatic valve disease | Blood cultures. Identification system and time to positivity not reported | Yes/Yes | Sensitive: LVX, MIN, CMX | VAN + TZP for 5 days, then MER + VAN + LVX for 9 days | Death on day 14 of admission |
| Stryjewski M, et al. [2]—2020 | Sepsis, Multiple Organ Failure, and Death Due to Pandoraea pnomenusa Infection after Lung Transplantation | 30-year-old male | End-stage pulmonary sarcoidosis complicated by nocardiosis and mycetomas, undergoing bilateral cadaveric lung transplantation. Pre-transplant management with prednisone 50 mg daily and itraconazole 100 mg twice daily. | Blood cultures on transplant day, positive at 48 h. Initially identified as B. cepacia but later correctly identified by PCR and RFLP | Yes/Yes | Sensitive: IPM Resistant: CAZ, CIP, TZP, CMX | Post-transplant management with CAZ + VAN + ABLC + GCV for 8 days, then CAZ was switched to MER and then to IMI | Death on day 17 of admission |
| Bodendoerfer E, et al. [7]—2021 | Possible Prosthetic Valve Endocarditis by Pandoraea pnomenusa and Specific Virulence Mechanisms | 37-year-old male | Intravenous drug user, native valve endocarditis with requirement for biologic prosthetic valve replacement. Received management with AMC and Isavuconazol | Peripheral blood cultures, positive at 23 h; PICC blood cultures, positive at 14 h. Incubation with BacT/ALERT Virtuo system and genomic sequencing with QIAseq FX DNA Library Kit system. | Yes/Yes | Sensitive: TZP, CEF, IPM, CIP, LVX, CMX Resistant: PIP, CAZ, CAZ-AVI, MEM, MV, AMK, GEN, TOB | TGC empirical, then TZP for 21 days, then CMX for 21 days | Recovery after 42 days of antibiotic. Control cultures were negative. |
| Cubides—Diaz D, et al.—2022 | Pandoraea pnomenusa superinfection in a patient with SARS-CoV-2 pneumonia. First case in the literature. | 55-year-old male | Acute severe SARS-CoV-2 infection with superinfection by K. pneumonie and S. marcescens treated with CEF. | Respiratory secretion culture, positive at 48 h. MALDI-TOF identification | No/Yes | Sensitive: CMX Intermedium: CIP | MEM + LZD empirical, then CIP + CMX for 14 days | Recovery after 14 days of antibiotic |
Publisher’s Note: MDPI stays neutral with regard to jurisdictional claims in published maps and institutional affiliations. |
© 2022 by the authors. Licensee MDPI, Basel, Switzerland. This article is an open access article distributed under the terms and conditions of the Creative Commons Attribution (CC BY) license (https://creativecommons.org/licenses/by/4.0/).
Share and Cite
Cubides-Diaz, D.A.; Muñoz Angulo, N.; Martin Arsanios, D.A.; Ovalle Monroy, A.L.; Perdomo-Rodriguez, D.R.; Del-Portillo, M.P. Pandoraea pnomenusa Superinfection in a Patient with SARS-CoV-2 Pneumonia: First Case in the Literature. Infect. Dis. Rep. 2022, 14, 205-212. https://doi.org/10.3390/idr14020025
Cubides-Diaz DA, Muñoz Angulo N, Martin Arsanios DA, Ovalle Monroy AL, Perdomo-Rodriguez DR, Del-Portillo MP. Pandoraea pnomenusa Superinfection in a Patient with SARS-CoV-2 Pneumonia: First Case in the Literature. Infectious Disease Reports. 2022; 14(2):205-212. https://doi.org/10.3390/idr14020025
Chicago/Turabian StyleCubides-Diaz, Diego Alejandro, Natalia Muñoz Angulo, Daniel Augusto Martin Arsanios, Ana Lucia Ovalle Monroy, Daniel Ricardo Perdomo-Rodriguez, and Maria Paula Del-Portillo. 2022. "Pandoraea pnomenusa Superinfection in a Patient with SARS-CoV-2 Pneumonia: First Case in the Literature" Infectious Disease Reports 14, no. 2: 205-212. https://doi.org/10.3390/idr14020025
APA StyleCubides-Diaz, D. A., Muñoz Angulo, N., Martin Arsanios, D. A., Ovalle Monroy, A. L., Perdomo-Rodriguez, D. R., & Del-Portillo, M. P. (2022). Pandoraea pnomenusa Superinfection in a Patient with SARS-CoV-2 Pneumonia: First Case in the Literature. Infectious Disease Reports, 14(2), 205-212. https://doi.org/10.3390/idr14020025

